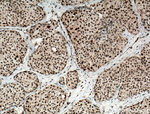
DPF2 Antibody in Immunohistochemistry (Paraffin) (IHC (P))

Search
Proteintech
DPF2 Polyclonal Antibody
{{$productOrderCtrl.translations['antibody.pdp.commerceCard.promotion.promotions']}}
{{$productOrderCtrl.translations['antibody.pdp.commerceCard.promotion.viewpromo']}}
{{$productOrderCtrl.translations['antibody.pdp.commerceCard.promotion.promocode']}}: {{promo.promoCode}} {{promo.promoTitle}} {{promo.promoDescription}}. {{$productOrderCtrl.translations['antibody.pdp.commerceCard.promotion.learnmore']}}
产品信息
12111-1-AP
种属反应
已发表种属
宿主/亚型
分类
类型
抗原
偶联物
形式
浓度
规格
纯化类型
保存液
内含物
保存条件
运输条件
产品详细信息
Immunogen sequence: MAAVVENVV KLLGEQYYKD AMEQCHNYNA RLCAERSVRL PFLDSQTGVA QSNCYIWMEK RHRGPGLASG QLYSYPARRW RKKRRAHPPE DPRLSFPSIK PDTDQTLKKE GLISQDGSSL EALLRTDPLE KRGAPDPRVD DDSLGEFPVT NSRARKRILE PDDFLDDLDD EDYEEDTPKR RGKGKSKGKG VGSARKKLDA SILEDRDKPY ACDICGKRYK NRPGLSYHYA HSHLAEEEGE DKEDSQPPTP VSQRSEEQKS KKGPDGLALP NNYCDFCLGD SKINKKTGQP EELVSCSDCG RSGHPSCLQF TPVMMAAVKT YRWQCIECKC CNICGTSEND DQLLFCDDCD RGYHMYCLTP SMSEPPEGSW SCHLCLDLLK EKASIYQNQN SS (1-391 aa encoded by BC014889)
靶标信息
The protein encoded by this gene is a member of the d4 domain family, characterized by a zinc finger-like structural motif. This protein functions as a transcription factor which is necessary for the apoptotic response following deprivation of survival factors. It likely serves a regulatory role in rapid hematopoietic cell growth and turnover. This gene is considered a candidate gene for multiple endocrine neoplasia type I, an inherited cancer syndrome involving multiple parathyroid, enteropancreatic, and pituitary tumors.
仅用于科研。不用于诊断过程。未经明确授权不得转售。
生物信息学
蛋白别名: Apoptosis response zinc finger protein; BAF45D; BRG1-associated factor 45D; D4, zinc and double PHD fingers family 2; neuro-d4/requiem; Protein requiem; requiem; requiem, apoptosis response zinc finger; unnamed protein product; Zinc finger protein ubi-d4; zinc finger; contains one C2H2 and two C4HC3
基因别名: 2210010M07Rik; BAF45D; CSS7; DPF2; REQ; SMARCG2; ubi-d4; UBID4
UniProt ID: (Human) Q92785, (Mouse) Q61103
Entrez Gene ID: (Human) 5977, (Rat) 361711, (Mouse) 19708